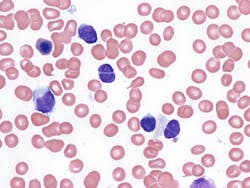
694aa9a342810da700bbbab6 Dreamstime Xxl 283644066 694aa9a342810da700bbbab6 Dreamstime Xxl 283644066

Roche's Lunsumio VELO approved by FDA for subcutaneous use in R/R follicular lymphoma
Roche announced that the US Food and Drug Administration (FDA) has approved CD20xCD3 bispecific Lunsumio VELO (mosunetuzumab), as a subcutaneous (SC) formulation, for the treatment of adult patients with relapsed or refractory (R/R) follicular lymphoma (FL) after two or more lines of systemic therapy, based on results from the phase I/II GO29781 study.
Based on the study results, Lunsumio VELO is approved under accelerated approval. Full approval for this regimen may be contingent on verification and confirmation of benefit in a confirmatory trial.
Lunsumio VELO reduces treatment administration time with an approximately one-minute injection, compared with a 2-4 hour intravenous (IV) infusion. Like Lunsumio administered intravenously, Lunsumio VELO can be administered outpatient and is a fixed-duration treatment given for a defined period, which could be as short as six months. By contrast, treat-to-progression treatment options are designed to be given to patients indefinitely until disease progression or until treatment can no longer be tolerated.
The FDA approval is supported by the primary analysis of the GO29781 study that evaluated Lunsumio VELO in patients with third-line or later (3L+) FL. Results showed the objective response rate and complete response rate in patients treated with Lunsumio VELO were 75% (95% confidence interval [CI]: 64–83%) and 59% (95% CI: 48–69%), respectively. The median duration of response was 22.4 months (95% CI: 16.8–22.8). The most common adverse reactions (≥20%) were injection site reactions, fatigue, rash, cytokine release syndrome (CRS), COVID-19 infection, musculoskeletal pain and diarrhea. The CRS rate was 30% and events were mostly low grade (Grade 1–2, 28%; Grade 3, 2.1%), occurred during Cycle 1, and all resolved after a median duration of two days (range: 1–15). CRS can be severe and life-threatening.
Lunsumio IV was the first bispecific antibody approved for 3L+ FL. Long-term data from the SC and IV arms of the GO29781 study were presented at the 67th American Society of Hematology Annual Meeting and Exposition.
These data have been submitted to other healthcare authorities around the world. Recently, the European Commission granted conditional marketing authorization of Lunsumio SC for the treatment of adult patients with R/R FL after two or more lines of systemic therapy.